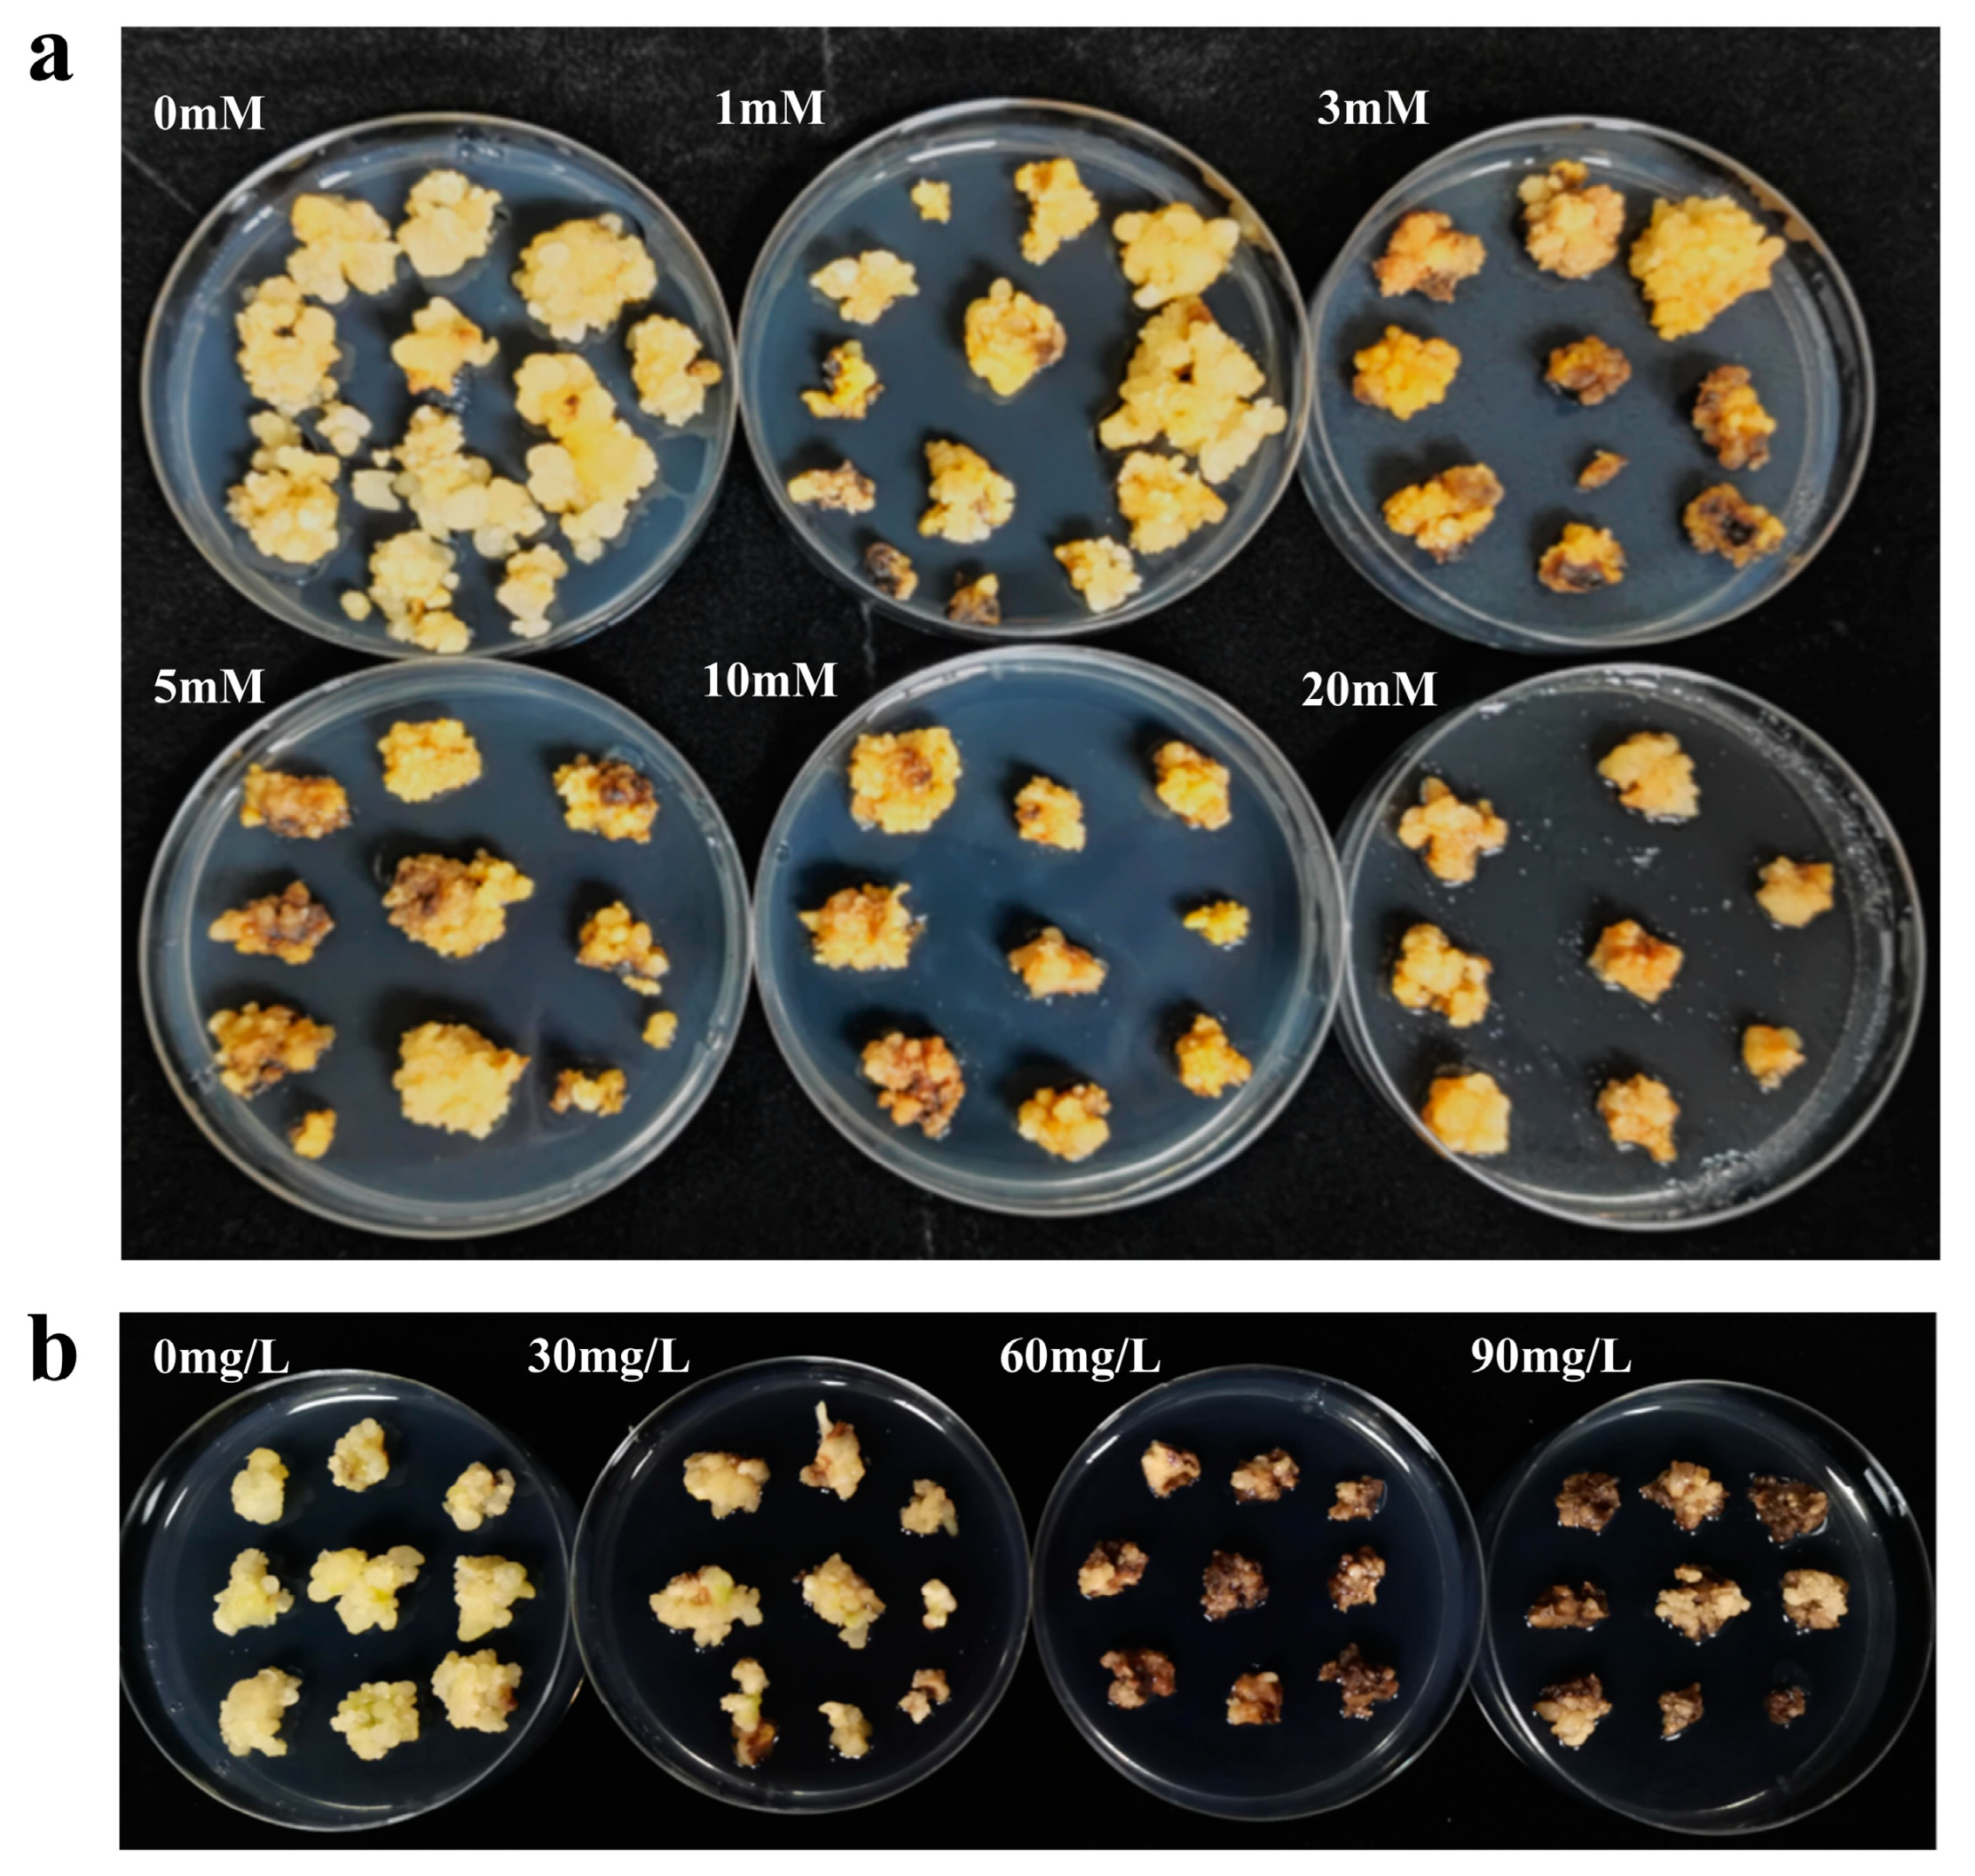
Plants 13 03343 g001

Highly Efficient Agrobacterium tumefaciens Mediated Transformation of Oil Palm Using an EPSPS-Glyphosate Selection System
Abstract
1. Introduction
2. Results
2.1. Determination of the Minimum Inhibitory Concentration of Glyphosate
2.2. Construction of the pCGlyDESCLⅠ-C for Oil Palm Transformation
2.3. Optimization of Agrobacterium-Mediated Genetic Transformation
2.4. Stable Transformation Using the TIPS-EiEPSPS/Glyphosate Selection System
2.5. Molecular and RFP Analysis of Glyphosate-Resistant Callus in Oil Palm
3. Discussion
4. Materials and Methods
4.1. Plant Materials and Culture Medium
4.2. Codon Optimization and Vectors Construction
4.3. Transformation of Oil Palm Embryonic Callus (EC)
4.4. Observation of RFP Under Fluorescence Microscopy
4.5. Genomic DNA Extraction and Polymerase Chain Reaction (PCR)
4.6. Southern Blot Analysis
4.7. Statistical Analysis
5. Conclusions
Supplementary Materials
Author Contributions
Funding
Data Availability Statement
Acknowledgments
Conflicts of Interest
References
- Sargeant, H.J. Oil palm agriculture in the wetlands of Sumatra: Destruction or development. Eur. Union. Minist. For. Bruss. 2001, 2, 8–9. [Google Scholar]
- Basiron, Y. Palm oil production through sustainable plantations. Eur. J. Lipid Sci. Technol. 2007, 109, 289–295. [Google Scholar] [CrossRef]
- Singh, R.; Low, E.T.; Ooi, L.C.; Ong-Abdullah, M.; Ting, N.C.; Nagappan, J.; Nookiah, R.; Amiruddin, M.D.; Rosli, R.; Manaf, M.A.; et al. The oil palm SHELL gene controls oil yield and encodes a homologue of SEEDSTICK. Nature 2013, 500, 340–344. [Google Scholar] [CrossRef] [PubMed]
- Jalani, B.S.; Cheah, S.C.; Rajanaidu, N.; Darus, A. Improvement of palm oil through breeding and biotechnology. J. Am. Oil Chem. Soc. 1997, 74, 1451–1455. [Google Scholar] [CrossRef]
- Sambanthamurthi, R.; Sundram, K.; Tan, Y.-A. Chemistry and biochemistry of palm oil. Prog. Lipid Res. 2000, 39, 507–558. [Google Scholar] [CrossRef] [PubMed]
- Cheah, S.-C.; Sambanthamurthi, R.; Abdullah, S.N.A.; Othman, A.; Manaf, M.A.A.; Ramli, U.S.; Kadir, A.P.G. Towards Genetic Engineering of Oil Palm (Elaeis guineensis Jacq.). Plant Lipid Metab. 1995, 5, 570–572. [Google Scholar] [CrossRef]
- Parveez, G.K.A.; Chowdhury, M.; Saleh, N.M. Determination of minimal inhibitory concentration of selection agents for oil palm (Elaeis guineensis Jacq.) transformation. Asia-Pac. J. Mol. Biol. Biotechnol. 1996, 4, 219–228. [Google Scholar]
- Masani, M.Y.A.; Izawati, A.M.D.; Rasid, O.A.; Parveez, G.K.A. Biotechnology of oil palm: Current status of oil palm genetic transformation. Biocatal. Agric. Biotechnol. 2018, 15, 335–347. [Google Scholar] [CrossRef]
- Yarra, R.; Jin, L.; Zhao, Z.; Cao, H. Progress in Tissue Culture and Genetic Transformation of Oil Palm: An Overview. Int. J. Mol. Sci. 2019, 20, 5353. [Google Scholar] [CrossRef] [PubMed]
- Parveez, G. Optimization of Parameters Involved in the Transformation of Oil Palm Using the Biolistic Method. Ph.D. Thesis, Universiti Putra Malaysia Serdang, Selangor, Malaysia, 1998. [Google Scholar]
- Masani, M.Y.; Noll, G.A.; Parveez, G.K.; Sambanthamurthi, R.; Prufer, D. Efficient transformation of oil palm protoplasts by PEG-mediated transfection and DNA microinjection. PLoS ONE 2014, 9, e96831. [Google Scholar] [CrossRef] [PubMed]
- Kadir, G.; Parveez, A. Production of transgenic oil palm (Elaeis guinensis JACQ.) using biolistic techniques. In Molecular Biology of Woody Plants; Springer: Berlin/Heidelberg, Germany, 2000; Volume 2, pp. 327–350. [Google Scholar]
- Masli, D.I.A.; Kadir, A.P.G.; Yunus, A.M.M. Transformation of oil palm using Agrobacterium tumefaciens. J. Oil Palm Res. 2009, 21, 643–652. [Google Scholar]
- Izawati, A.M.; Masani, M.Y.; Ismanizan, I.; Parveez, G.K. Evaluation on the effectiveness of 2-deoxyglucose-6-phosphate phosphatase (DOG(R)1) gene as a selectable marker for oil palm (Elaeis guineensis Jacq.) embryogenic calli transformation mediated by Agrobacterium tumefaciens. Front. Plant. Sci. 2015, 6, 727. [Google Scholar] [CrossRef]
- Yu, Q.; Jalaludin, A.; Han, H.; Chen, M.; Sammons, R.D.; Powles, S.B. Evolution of a double amino acid substitution in the 5-enolpyruvylshikimate-3-phosphate synthase in Eleusine indica conferring high-level glyphosate resistance. Plant Physiol. 2015, 167, 1440–1447. [Google Scholar] [CrossRef]
- Gaines, T.A.; Patterson, E.L.; Neve, P. Molecular mechanisms of adaptive evolution revealed by global selection for glyphosate resistance. New Phytol. 2019, 223, 1770–1775. [Google Scholar] [CrossRef]
- Lu, L.; Han, Q.; Li, L.; Zhou, L.; Liu, R.; Song, Z.; Shen, Z.; Shou, H. Establishment of an efficient transformation protocol for soybean using glyphosate as selective agent and the development of glyphosate-tolerant transgenic soybean lines. Sci. Sin. Vitae 2014, 44, 406–415. [Google Scholar]
- Zhou, H.; Arrowsmith, J.; Fromm, M.; Hironaka, C.; Taylor, M.; Rodriguez, D.; Pajeau, M.; Brown, S.; Santino, C.; Fry, J. Glyphosate-tolerant CP4 and GOX genes as a selectable marker in wheat transformation. Plant Cell Rep. 1995, 15, 159–163. [Google Scholar] [CrossRef]
- Cao, G.; Liu, Y.; Zhang, S.; Yang, X.; Chen, R.; Zhang, Y.; Lu, W.; Liu, Y.; Wang, J.; Lin, M. A novel 5-enolpyruvylshikimate-3-phosphate synthase shows high glyphosate tolerance in Escherichia coli and tobacco plants. PLoS ONE 2012, 7, e38718. [Google Scholar] [CrossRef]
- Ren, Z.-J.; Cao, G.-Y.; Zhang, Y.-W.; Yan, L.; Liu, Y.-J. Overexpression of a modified AM79 aroA gene in transgenic maize confers high tolerance to glyphosate. J. Integr. Agric. 2015, 14, 414–422. [Google Scholar] [CrossRef]
- Cui, Y.; Huang, S.; Liu, Z.; Yi, S.; Zhou, F.; Chen, H.; Lin, Y. Development of novel glyphosate-tolerant japonica rice lines: A step toward commercial release. Front. Plant Sci. 2016, 7, 1218. [Google Scholar] [CrossRef]
- Liu, Y.; Zhang, Y.; Liu, Y.; Lu, W.; Wang, G. Metabolic effects of glyphosate on transgenic maize expressing a G2-EPSPS gene from Pseudomonas fluorescens. J. Plant Biochem. Biotechnol. 2015, 24, 233–241. [Google Scholar] [CrossRef]
- He, F.; Lang, Z.; Lu, W.; Lin, M.; Zhang, J.; Huang, D. The establishment of maize transformation system with a glyphosate-tolerant 2mG2-epsps gene as a selectable marker. Biotechnol. Bull. 2008, 5, 92–97. [Google Scholar]
- Guo, B.-F.; Hong, H.-L.; Han, J.-N.; Zhang, L.-J.; Liu, Z.-X.; Yong, G.; Qiu, L.-J. Development and identification of glyphosate-tolerant transgenic soybean via direct selection with glyphosate. J. Integr. Agric. 2020, 19, 1186–1196. [Google Scholar] [CrossRef]
- Spencer, M.; Mumm, R.; Gwyn, J. Glyphosate Resistant Maize Lines. U.S. Patent 6,040,497, 21 March 2000. [Google Scholar]
- Ouyang, C.; Liu, W.; Chen, S.; Zhao, H.; Chen, X.; Jin, X.; Li, X.; Wu, Y.; Zeng, X.; Huang, P.; et al. The Naturally Evolved EPSPS From Goosegrass Confers High Glyphosate Resistance to Rice. Front. Plant Sci. 2021, 12, 756116. [Google Scholar] [CrossRef] [PubMed]
- Howe, A.R.; Gasser, C.S.; Brown, S.M.; Padgette, S.R.; Hart, J.; Parker, G.B.; Fromm, M.E.; Armstrong, C.L. Glyphosate as a selective agent for the production of fertile transgenic maize (Zea mays L.) plants. Mol. Breed. 2002, 10, 153–164. [Google Scholar] [CrossRef]
- Hu, T.; Metz, S.; Chay, C.; Zhou, H.; Biest, N.; Chen, G.; Cheng, M.; Feng, X.; Radionenko, M.; Lu, F. Agrobacterium-mediated large-scale transformation of wheat (Triticum aestivum L.) using glyphosate selection. Plant Cell Rep. 2003, 21, 1010–1019. [Google Scholar] [PubMed]
- Padgette, S.R.; Kolacz, K.H.; Delannay, X.; Re, D.; LaVallee, B.; Tinius, C.; Rhodes, W.; Otero, Y.; Barry, G.; Eichholtz, D. Development, identification, and characterization of a glyphosate-tolerant soybean line. Crop Sci. 1995, 35, 1451–1461. [Google Scholar] [CrossRef]
- Clemente, T.E.; LaVallee, B.J.; Howe, A.R.; Conner-Ward, D.; Rozman, R.J.; Hunter, P.E.; Broyles, D.L.; Kasten, D.S.; Hinchee, M.A. Progeny analysis of glyphosate selected transgenic soybeans derived from Agrobacterium-mediated transformation. Crop Sci. 2000, 40, 797–803. [Google Scholar] [CrossRef]
- Soto, N.; Delgado, C.; Hernández, Y.; Rosabal, Y.; Ferreira, A.; Pujol, M.; Aragão, F.J.; Enríquez, G.A. Efficient particle bombardment-mediated transformation of Cuban soybean (INCASoy-36) using glyphosate as a selective agent. Plant Cell Tissue Organ Cult. (PCTOC) 2017, 128, 187–196. [Google Scholar] [CrossRef]
- Zhao, F.-Y.; Li, Y.-F.; Xu, P. Agrobacterium-mediated transformation of cotton (Gossypium hirsutum L. cv. Zhongmian 35) using glyphosate as a selectable marker. Biotechnol. Lett. 2006, 28, 1199–1207. [Google Scholar] [CrossRef]
- Wang, J.; Zhao, F.; Xu, P. Use of aroA-M1 as a Selectable Marker for Brassica napus Transformation. Crop Sci. 2006, 46, 706–711. [Google Scholar] [CrossRef]
- Bindels, D.S.; Haarbosch, L.; Van Weeren, L.; Postma, M.; Wiese, K.E.; Mastop, M.; Aumonier, S.; Gotthard, G.; Royant, A.; Hink, M.A. mScarlet: A bright monomeric red fluorescent protein for cellular imaging. Nat. Methods 2017, 14, 53–56. [Google Scholar] [CrossRef] [PubMed]
- Nurfahisza, A.R.; Rafiqah, M.A.; Masani, M.Y.A.; Hanin, A.N.; Rasid, O.A.; Parveez, G.K.A.; Ismail, I. Molecular analysis of transgenic oil palm to detect the presence of transgenes. J. Oil Palm Res. 2014, 26, 73–80. [Google Scholar]
- Bahariah, B.; Parveez, G.K.A.; Khalid, N. Determining the optimal concentration of mannose as an effective selection agent for transformed oil palm cells using the phosphomannose isomerase (pmi) gene as a positive selectable marker. J. Oil Palm Res. 2012, 24, 1250–1259. [Google Scholar]
- Bahariah, B.; Parveez, G.K.A.; Masani, M.Y.A.; Masura, S.S.; Khalid, N.; Othman, R.Y. Biolistic transformation of oil palm using the phosphomannose isomerase (pmi) gene as a positive selectable marker. Biocatal. Agric. Biotechnol. 2013, 2, 295–304. [Google Scholar] [CrossRef]
- Wenck, A.; Hansen, G. Positive selection. Transgenic Plants Methods Protoc. 2004, 286, 227–235. [Google Scholar]
- Yenchon, S.; Te-chato, S. Effect of bacteria density, inoculation and co-cultivation period on Agrobacterium-mediated transformation of oil palm embryogenic callus. J. Agric. Technol. 2012, 8, 1485–1496. [Google Scholar]
- Te, Z.; LIN, C.-y.; SHEN, Z.-c. Development of transgenic glyphosate-resistant rice with G6 gene encoding 5-enolpyruvylshikimate-3-phosphate synthase. Agric. Sci. China 2011, 10, 1307–1312. [Google Scholar]
- Parveez, G.K.A.; Chowdhury, M.; Saleh, N.M. Biological parameters affecting transient GUS gene expression in oil palm (Elaeis guineensis Jacq.) embryogenic calli via microprojectile bombardment. Ind. Crops Prod. 1998, 8, 17–27. [Google Scholar] [CrossRef]
- Parveez, G.K.; Rasid, O.A.; Masani, M.Y.; Sambanthamurthi, R. Biotechnology of oil palm: Strategies towards manipulation of lipid content and composition. Plant Cell Rep. 2015, 34, 533–543. [Google Scholar] [CrossRef]
- Zou, J.; Zhang, Q.; Zhu, Z.; Gao, L.; Zheng, Y.; Li, D. Embryogenic callus induction and fatty acid composition analysis of oil palm (Elaeis guineensis cv. Tenera). Sci. Hortic. 2019, 245, 125–130. [Google Scholar] [CrossRef]
- Kalla, R.; Shimamoto, K.; Potter, R.; Nielsen, P.S.; Linnestad, C.; Olsen, O.A. The promoter of the barley aleurone-specific gene encoding a putative 7 kDa lipid transfer protein confers aleurone cell-specific expression in transgenic rice. Plant J. 1994, 6, 849–860. [Google Scholar] [CrossRef] [PubMed]
- Hajdukiewicz, P. The small, versatilepPZP family ofAgrobacterium binary vectors for plant transformation. Plant Mol. Biol. 1994, 25, 989–994. [Google Scholar] [CrossRef] [PubMed]
- Southern, E.M. Detection of specific sequences among DNA fragments separated by gel electrophoresis. J. Mol. Biol. 1975, 98, 503–517. [Google Scholar] [CrossRef] [PubMed]
- Green, M.R.; Sambrook, J. Molecular Cloning: A Laboratory Manual, 4th ed.; Cold Spring Harbor Laboratory Press: Long Island, NY, USA, 2012. [Google Scholar]

| Medium + Selection Agents | Non-Transgenic Calli | ||
|---|---|---|---|
| No. of Calli Cultured | No. of Newly Grown Calli | Ratios of Newly Grown Calli | |
| EgcSM | 45 | 43 | 95.56% ± 3.85% |
| EgcSM + glyphosate 1 mM | 39 | 13 | 33.33% ± 4.44% |
| EgcSM + glyphosate 3 mM | 30 | 0 | 0.00% |
| EgcSM + glyphosate 5 mM | 30 | 0 | 0.00% |
| EgcSM + glyphosate 10 mM | 27 | 0 | 0.00% |
| EgcSM + glyphosate 20 mM | 24 | 0 | 0.00% |
| EgcSM | 27 | 27 | 100% |
| EgcSM + hygromycin 30 mg/L | 27 | 13 | 48.15% ± 6.42% |
| EgcSM + hygromycin 60 mg/L | 27 | 0 | 0.00% |
| EgcSM + hygromycin 90 mg/L | 27 | 0 | 0.00% |
| Test Groups | Cleaning with Sterile Water | Cleaning with Antibiotic Solution | Antibiotics of Selection Medium | Proliferation of A. tumefaciens | Ratio of RFP Calli (%) |
|---|---|---|---|---|---|
| A + 400 Cs | Sterile Water | Sterile Water + 400 mg/L T | 400 mg/L Cs | ++ | 1.96 ± 3.40 bc |
| A + 400 T | Sterile Water | Sterile Water + 400 mg/L T | 400 mg/L T | ++ | 2.08 ± 3.61 bc |
| B + 400 Cs | Sterile Water + T + Tween | Sterile Water + 400 mg/L T | 400 mg/L Cs | +++ | 0.00 ± 0.00 c |
| B + 400 T | Sterile Water + T + Tween | Sterile Water + 400 mg/L T | 400 mg/L T | +++ | 0.00 ± 0.00 c |
| C + 400 Cs | Sterile Water | Sterile Water + 400 mg/L Cs | 400 mg/L Cs | +++ | 0.00 ± 0.00 c |
| C + 400 T | Sterile Water | Sterile Water + 400 mg/L Cs | 400 mg/L T | +++ | 1.85 ± 3.21 bc |
| A + 500 Cs | Sterile Water | Sterile Water + 500 mg/L T | 500 mg/L Cs | − | 12.96 ± 3.21 ab |
| A + 500 T | Sterile Water | Sterile Water + 500 mg/L T | 500 mg/L T | − | 16.67 ± 2.62 a |
| B + 500 Cs | Sterile Water + T + Tween | Sterile Water + 500 mg/L T | 500 mg/L Cs | ++ | 2.22 ± 3.85 bc |
| B + 500 T | Sterile Water + T + Tween | Sterile Water + 500 mg/L T | 500 mg/L T | ++ | 4.17 ± 3.61 bc |
| C + 500 Cs | Sterile Water | Sterile Water + 500 mg/L Cs | 500 mg/L Cs | + | 6.67 ± 2.31 bc |
| C + 500 T | Sterile Water | Sterile Water + 500 mg/L Cs | 500 mg/L T | − | 8.33 ± 2.89 b |
Disclaimer/Publisher’s Note: The statements, opinions and data contained in all publications are solely those of the individual author(s) and contributor(s) and not of MDPI and/or the editor(s). MDPI and/or the editor(s) disclaim responsibility for any injury to people or property resulting from any ideas, methods, instructions or products referred to in the content. |
© 2024 by the authors. Licensee MDPI, Basel, Switzerland. This article is an open access article distributed under the terms and conditions of the Creative Commons Attribution (CC BY) license (https://creativecommons.org/licenses/by/4.0/).
Share and Cite
Ouyang, C.; Jin, X.; Guo, Q.; Luo, S.; Zheng, Y.; Zou, J.; An, B.; Li, D. Highly Efficient Agrobacterium tumefaciens Mediated Transformation of Oil Palm Using an EPSPS-Glyphosate Selection System. Plants 2024, 13, 3343. https://doi.org/10.3390/plants13233343
Ouyang C, Jin X, Guo Q, Luo S, Zheng Y, Zou J, An B, Li D. Highly Efficient Agrobacterium tumefaciens Mediated Transformation of Oil Palm Using an EPSPS-Glyphosate Selection System. Plants. 2024; 13(23):3343. https://doi.org/10.3390/plants13233343
Chicago/Turabian StyleOuyang, Chao, Xiongxia Jin, Qinghui Guo, Shaojie Luo, Yusheng Zheng, Jixin Zou, Baoguang An, and Dongdong Li. 2024. "Highly Efficient Agrobacterium tumefaciens Mediated Transformation of Oil Palm Using an EPSPS-Glyphosate Selection System" Plants 13, no. 23: 3343. https://doi.org/10.3390/plants13233343
APA StyleOuyang, C., Jin, X., Guo, Q., Luo, S., Zheng, Y., Zou, J., An, B., & Li, D. (2024). Highly Efficient Agrobacterium tumefaciens Mediated Transformation of Oil Palm Using an EPSPS-Glyphosate Selection System. Plants, 13(23), 3343. https://doi.org/10.3390/plants13233343

